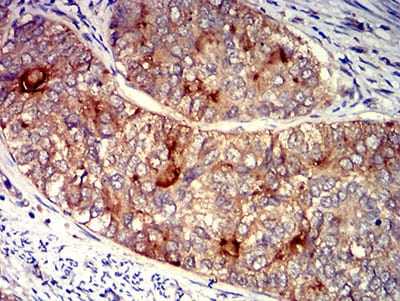

-
分类: 科研抗体货号: 31430别名: LY9B; hCD84; mCD84; SLAMF5应用: FCM反应种属: Human
-
分类: 科研抗体货号: 31414别名: TNFRSF13C; BAFFR; CVID4; BAFF-R; BROMIX; prolixin应用: WB,FCM反应种属: Human,Rat
-
分类: 科研抗体货号: 31399别名: HAP; BAG-1; RAP46应用: IF,FCM反应种属: Human
-
分类: 科研抗体货号: 31429别名: LY9B; hCD84; mCD84; SLAMF5应用: FCM反应种属: Human
-
分类: 科研抗体货号: 31413别名: TNFRSF13C; BAFFR; CVID4; BAFF-R; BROMIX; prolixin应用: FCM反应种属: Human
-
分类: 科研抗体货号: 31398别名: FOLH1; PSM; FGCP; FOLH; GCP2; mGCP; GCPII; NAALAD1; NAALAdase应用: WB,FCM反应种属: Human
-
分类: 科研抗体货号: 31428别名: IN; LHR; MC56; MDU2; MDU3; MIC4; Pgp1; CDW44; CSPG8; HCELL; HUTCH-I; ECMR-III应用: WB,IHC,FCM反应种属: Human
-
分类: 科研抗体货号: 31412别名: IL9R; IL-9R应用: WB,IHC,FCM反应种属: Human,Rat
-
分类: 科研抗体货号: 31397别名: FBP; FOLR应用: IHC,IF,FCM反应种属: Human
-
分类: 科研抗体货号: 31427别名: IN; LHR; MC56; MDU2; MDU3; MIC4; Pgp1; CDW44; CSPG8; HCELL; HUTCH-I; ECMR-III应用: WB,IHC,FCM反应种属: Human

鄂公网安备42018502007531号
鄂公网安备42018502007531号

